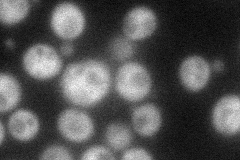
YDR422C
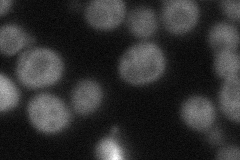
YDR422C
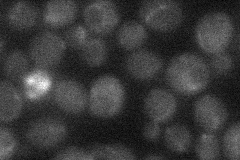
YDR422C
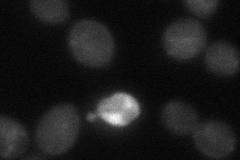
YDR422C
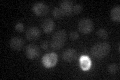
YDR422C

View description
Alternate beta-subunit of the Snf1p kinase complex, may confer substrate specificity; vacuolar protein containing KIS (Kinase-Interacting Sequence) and ASC (Association with Snf1 kinase Complex) domains involved in protein interactions
Localization:
Intensity:
Fold change:
Significance:
-
C’ GFP library in SD

cytosol19.14 -
N' NOP1pr-GFP in SD
cytosol57.0055 -
N' TEF2pr-mCherry in SD
cytosol39.851 -
N' NATIVEpr-GFP in SD
below threshold20.1917 -
N' TEF2pr-VC and Cyto-VN in SD
cytosol36.0243 -
C’ GFP library in SD+DTT

cytosol21.271.11No -
C’ GFP library in SD+H2O2

punctate16.920.88No -
C’ GFP library in Starvation Media
cytosol17.110.89No -
C’ GFP library on the background of Pup2-DaMP

cytosol -
C’ GFP library on the background of CCT mutant

cytosol16.80610.877316No
